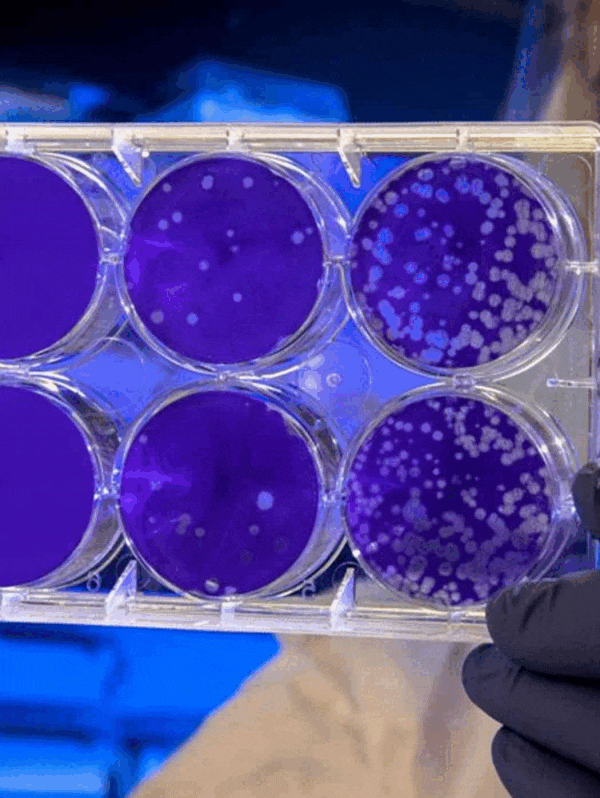

스타벅스 텀블러 추천 그로서리마켓 피비 워터보틀 조이 콜드컵 나수 엘마
2025.09.27

스타벅스 텀블러 추천 그로서리마켓 피비 워터보틀 조이 콜드컵 나수 엘마 안녕하세요 팅커벨라 입니다. 오...
출처
https://blog.naver.com/andher/224023717555
이슈모어 핫이슈
-
 사라진 이름이 아니라 남아 있는 얼굴, 미스코리아 출신 박시연의 현재
박시연이라는 이름은 한동안 대중문화의 중심에서 다소 멀어져 있었지만, 완전히 사라진 적은 없었다. 미스코리아…
사라진 이름이 아니라 남아 있는 얼굴, 미스코리아 출신 박시연의 현재
박시연이라는 이름은 한동안 대중문화의 중심에서 다소 멀어져 있었지만, 완전히 사라진 적은 없었다. 미스코리아…
-
 ‘오늘부터 인간입니다만’에서 존재감 포착… 이시우, 조용히 시작된 얼굴 각인
‘오늘부터 인간입니다만’으로 얼굴 각인, 신인 배우가 남긴 첫 인상 이시우가 SBS 드라마 ‘오늘부터 인간입…
‘오늘부터 인간입니다만’에서 존재감 포착… 이시우, 조용히 시작된 얼굴 각인
‘오늘부터 인간입니다만’으로 얼굴 각인, 신인 배우가 남긴 첫 인상 이시우가 SBS 드라마 ‘오늘부터 인간입…
-
 현아, 논란 대신 음악을 택했다… ‘못(Mrs. Nail)’로 드러난 현재형 선택
돌아온 현아, 논란 대신 음악으로 증명한 현재형 존재감 현아가 다시 음악으로 자신의 현재를 증명하고 있다. …
현아, 논란 대신 음악을 택했다… ‘못(Mrs. Nail)’로 드러난 현재형 선택
돌아온 현아, 논란 대신 음악으로 증명한 현재형 존재감 현아가 다시 음악으로 자신의 현재를 증명하고 있다. …
관련 포스팅
Copyright blog.dowoo.me All right reserved.